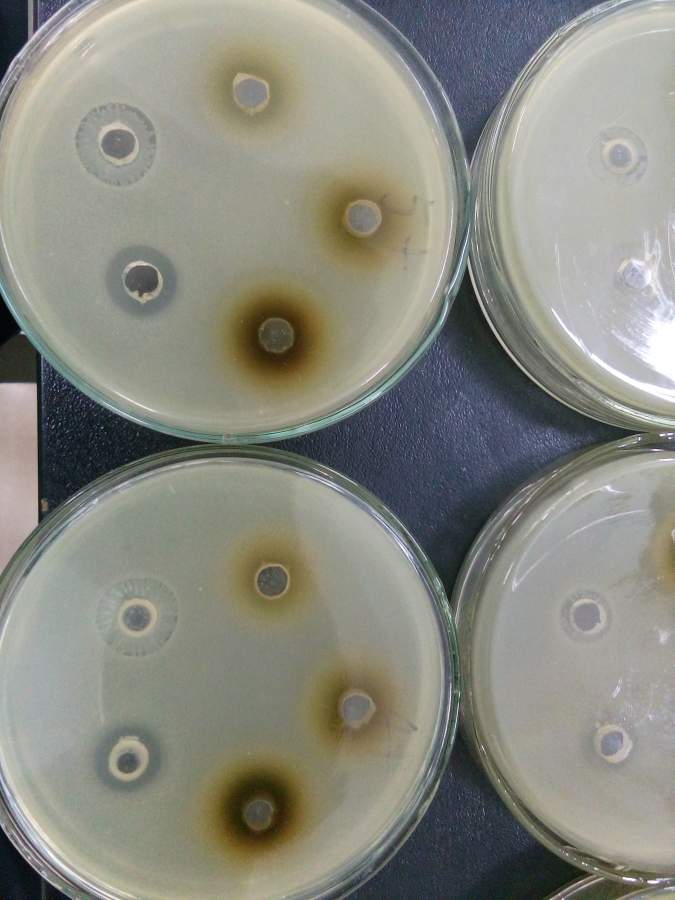
氨苄青霉素抑菌圈总是长满菌

氨苄青霉素肌肉注射

注射用氨苄青霉素钠
图片尺寸2144x1424
氨苄青霉素储存液(100mg/ml).
图片尺寸597x597
注射用氨苄青霉素钠 国药威奇达药业有限公司功效与主治:本品适用于
图片尺寸422x403
氨苄青霉素(ampicillin)
图片尺寸3508x2480
氨苄青霉素药物分子.它是-内酰胺抗生素.结构化学式和分子模型
图片尺寸1200x800
将完成导入过程后的细菌涂布在含有氨苄青霉素的培养基上,能生长的就
图片尺寸477x177
氨苄青霉素结构式
图片尺寸1200x840
苄星青霉素两种肌注方法在风心病中的应用比较
图片尺寸1439x1996
氨苄青霉素溶液51ml
图片尺寸1000x1000
氨苄青霉素
图片尺寸360x342
霉素类比如:青霉素,链霉素,红霉素,氯霉素,氨苄青霉素,万古霉素
图片尺寸3854x5781
氨苄青霉素钠(氨苄青霉素钠盐怎么配氨苄)
图片尺寸600x600
氨苄青霉素溶液
图片尺寸650x650
胶囊剂的具体用法用量如下:◆严重感染时,阿莫西林注射剂可与舒巴坦按
图片尺寸960x661
(早期药品说明)――四星牌 注射用氨苄青霉素钠 使用 说明书
图片尺寸1200x1200
一,10%葡萄糖注射2000毫升,氨苄青霉素25支,环丙沙星适量,用法:一次
图片尺寸1920x1440
ny/t 829-2004 牛奶中氨苄青霉素残留检测方法——hplc 仪器谱
图片尺寸591x837
氨苄青霉素治疗流行性脑脊髓膜炎
图片尺寸250x347
氨苄青霉素抑菌圈总是长满菌
图片尺寸675x900
氨苄青霉素|氨苄西林三水酸|水合氨苄青霉素99%|7177-48-2|用途
图片尺寸1000x801